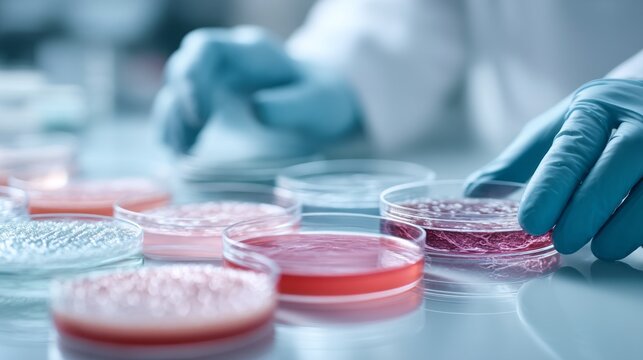
A scientist in a lab coat uses gloved hands to carefully arrange multiple petri dishes filled with various cultures. The colorful contents reflect innovative research efforts

- Home >
- Stock Photos >
- Diverse Scientists Collaborating in Modern Laboratory Research
Diverse Scientists Collaborating in Modern Laboratory Research Image

Scientists from different backgrounds collaborating on research in a modern laboratory. They are using technology and equipment, showing teamwork and investigation. This visual is ideal for topics related to diversity in science, collaborative research, and technological progression in laboratories.
Credit Photo
If you would like to credit the Photo, here are some ways you can do so
Text Link
photo Link
<span class="text-link">
<span>
<a target="_blank" href=https://pikwizard.com/photo/diverse-scientists-collaborating-in-modern-laboratory-research/4406ce749e218ef8b1ff1c9b5969f228/>PikWizard</a>
</span>
</span>
<span class="image-link">
<span
style="margin: 0 0 20px 0; display: inline-block; vertical-align: middle; width: 100%;"
>
<a
target="_blank"
href="https://pikwizard.com/photo/diverse-scientists-collaborating-in-modern-laboratory-research/4406ce749e218ef8b1ff1c9b5969f228/"
style="text-decoration: none; font-size: 10px; margin: 0;"
>
<img src="https://pikwizard.com/pw/medium/4406ce749e218ef8b1ff1c9b5969f228.jpg" style="margin: 0; width: 100%;" alt="" />
<p style="font-size: 12px; margin: 0;">PikWizard</p>
</a>
</span>
</span>
Free (free of charge)
Free for personal and commercial use.
Author: People Creations